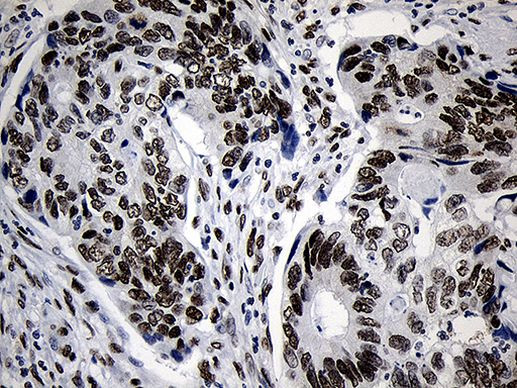
NABP1 Antibody in Immunohistochemistry (Paraffin) (IHC (P))

Search
Invitrogen
NABP1 Monoclonal Antibody (OTI6B10)
{{$productOrderCtrl.translations['antibody.pdp.commerceCard.promotion.promotions']}}
{{$productOrderCtrl.translations['antibody.pdp.commerceCard.promotion.viewpromo']}}
{{$productOrderCtrl.translations['antibody.pdp.commerceCard.promotion.promocode']}}: {{promo.promoCode}} {{promo.promoTitle}} {{promo.promoDescription}}. {{$productOrderCtrl.translations['antibody.pdp.commerceCard.promotion.learnmore']}}
图: 1 / 9
NABP1 Antibody (MA5-27390) in IHC (P)









Please note: We are reviewing Western blot images included in the antibody testing data in our catalog, including those provided by third parties. Unless expressly labeled or annotated as “raw-unedited”, Western blot images included in the antibody testing data in our catalog may have been edited, optimized or otherwise adjusted for presentation.
产品信息
MA5-27390
种属反应
宿主/亚型
分类
类型
克隆号
抗原
偶联物
形式
浓度
规格
纯化类型
保存液
内含物
保存条件
运输条件
RRID
靶标信息
NABP1, also known as NABP1/Ssb2, is a single-stranded DNA-binding protein involved in genome maintenance and stability. The gene encoding NABP1 is regulated by RORgamma2, a retinoid-related orphan receptor critical for thymopoiesis. Research has demonstrated that NABP1 plays a compensatory role in thymic maturation, particularly in conditions where its homolog, SSB1, is knocked out. Despite SSB1's vital role in neonatal survival, NABP1 remains non-essential for thymic maturation and male fertility, indicating partial functional redundancy between these proteins. Furthermore, studies on the C-terminal regions of NABP1 have shown distinct roles in nucleic acid binding, contributing to DNA and RNA metabolism. These findings highlight NABP1's importance in genomic integrity and its complex interplay within cellular processes.
仅用于科研。不用于诊断过程。未经明确授权不得转售。
篇参考文献 (0)
生物信息学
蛋白别名: hSSB2; Nucleic acid-binding protein 1; Oligonucleotide/oligosaccharide-binding fold-containing protein 2A; Sensor of single-strand DNA complex subunit B2; Sensor of ssDNA subunit B2; Single-stranded DNA-binding protein 2; SOSS complex subunit B2; SOSS-B2
基因别名: NABP1; OBFC2A; SSB2
Entrez Gene ID: (Human) 64859